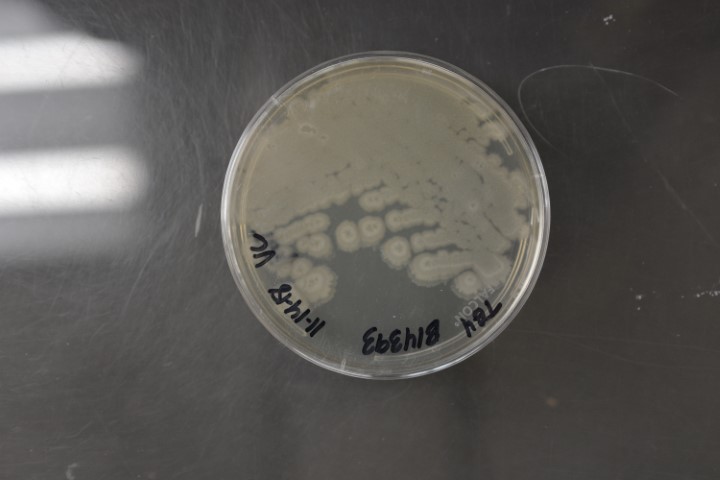

Zen_seeker
POTM Winner 🏆
- Joined
- Apr 16, 2023
- Messages
- 6,357
- Reaction score
- 24,552
No way. I would have been the richest teenager in my neighborhood.When was it that Quebec wanted to seperate from Canada? Maybe 77 or 78?
Word was that if they did seperate they would use Canadian tire money as their currency